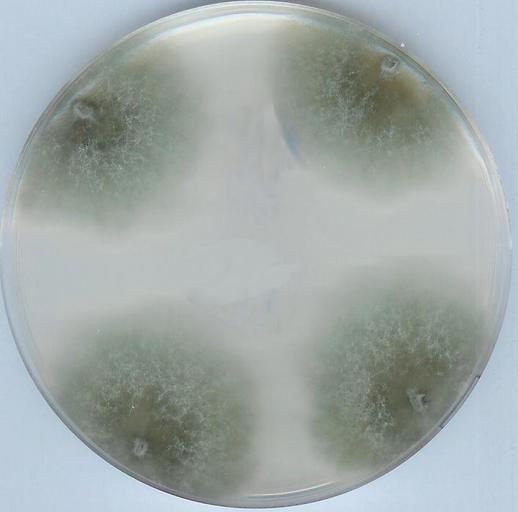

MAKE A MEME
View Large Image
| View Original: | Podospora anserina.jpg (706x698) | |||
| Download: | Original | Medium | Small | Thumb |
| Courtesy of: | commons.wikimedia.org | More Like This | ||
| Keywords: Podospora anserina.jpg fr Souche sauvage de Podospora anserina sur boite de Petri en Podospora anserina Wild type strain on a Petri dish Own Pierre Gr 2009-12-11 Podospora anserina Petri dishes cultures | ||||